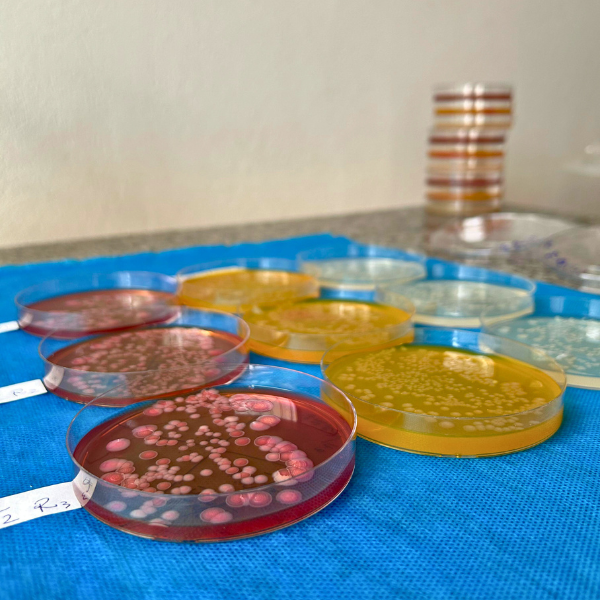

Serviços
Veja como nossas soluções podem atender suas necessidades agrícolas com qualidade, inovação e suporte técnico especializado.

Manejo dos principais fitopatógenos nos sistemas agrícolas
Fornecimento de Biofermentadores e biorreatores industriais em inox com tecnologia avançada e tanques refrigerados para armazenamento.
Produtos prontos para uso, inóculos, meios de cultura específicos, filtros e sanitizantes de alta qualidade.
Consultoria Especializada para produção de microrganismos na fazendas
